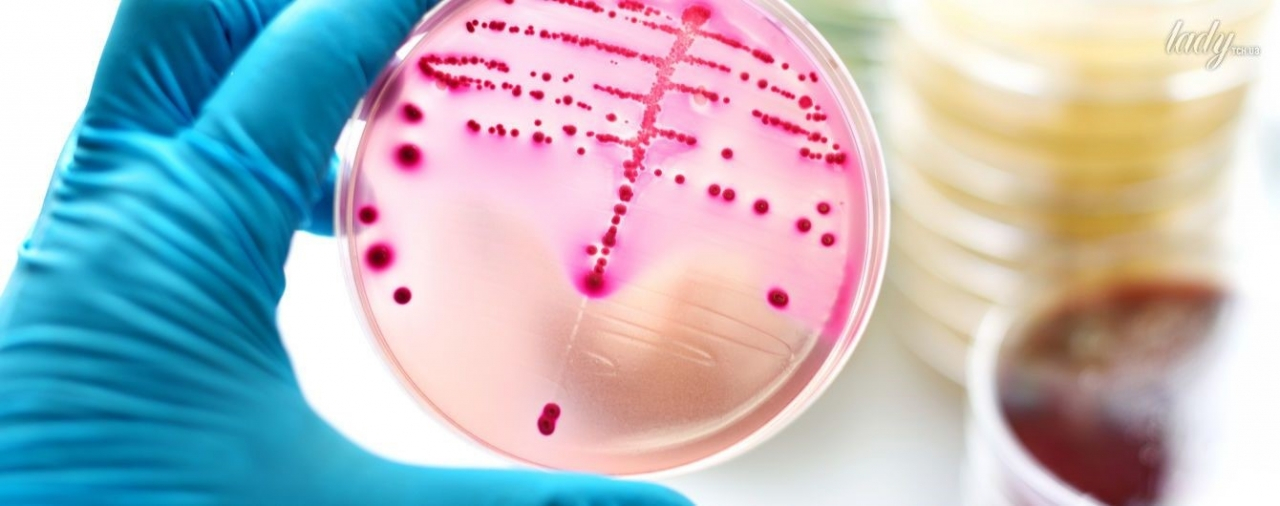
mamaplus

Воспаления горла (ангины или ОТФ - острые тонзиллофарингиты) - частое явление в возрасте от 3 до 15 лет, особенно в холодное время года, т.к. дети ходят в детские сады, школы и там «обмениваются» инфекциями.
Большинство случаев ОТФ у детей вызваны вирусами (адено-, рино-, коронавирусы, вирусы гриппа, парагриппа, Эпштейна — Барр, Коксаки и т. д.). Это принципиально важно, т. к. вирусные ОТФ не требуют назначения антибактериальной терапии (АБТ). Но в ряде случаев причиной ОТФ является Бета-гемолитический стрептококк А (БГСА): он обнаруживается в 10–15 % случаев ОТФ у детей до 5 лет, 20–37 % — в возрасте 5–15 лет.
ОРВИ не требует АБТ, поскольку, как доказано многочисленными исследованиями, при этом количество бактериальных осложнений не только не уменьшается, но, напротив, увеличивается, т.к. антибиотики убивают и полезные бактерии, которые защищают глотку от колонизации БГСА и другими патогенами. Кроме того, частое и неоправданное использование антибиотиков приводит к снижению общего иммунитета организма и появлению резистентных форм микробов.
К сожалению, клинически и при осмотре горла отличить острый вирусный тонзиллит от БГСА непросто. Что касается налетов на миндалинах, то они с одинаковой частотой присутствуют и при вирусных тонзиллитах (аденовирус, вирус Эпштейн-Барр) и при стрептококковой инфекции. Однако при стрептококковых тонзиллитах налеты появляются в первые сутки болезни, а при вирусных - обычно на 3–4-й день.
Лабораторные данные также не всегда позволяют отличить бактериальную инфекцию от вирусной.
Бактериологическое исследование (посев, мазок из горла) считается «золотым стандартом» диагностики стрептококкового ОТФ. При идеальном соблюдении всех требований (от забора мазка до интерпретации результата) его чувствительность превышает 90 %, а специфичность 95–99 %. Но реальность далека от идеала.
У бактериологического метода есть ряд недостатков:
-
Основной недостаток — длительность (не менее 3-5 дней в случае выявления БГСА). В этот период врач стоит перед выбором: назначить АБ, чтобы избежать осложнений, или воздержаться и взять на себя риск возможных осложнений. Поэтому более чем в 90% случаев назначаются антибиотики.
-
Многоэтапность, и вовлеченность в процесс большого количества людей. На любом из этапов что-то может повлиять на правильность результата (забор мазка, правильная маркировка пробы, условия перевозки, температурный режим, качество оборудования, питательных сред и реактивов, компетентность медперсонала, внимательность при заполнении медицинской документации и т.д.)
-
Высокая себестоимость метода! Не все медучреждения могут себе позволить содержать полноценную современную бак-лабораторию, оснащенную всем необходимым оборудованием.
-
Кроме того, возможно получение ложноотрицательных результатов посевов по нескольким причинам.
-
Во-первых, выделение стрептококков затруднено в тех случаях, когда наряду с ними в материале встречаются гемолитические стафилококки (Staphylococcus aureus), которые отличаются бурным ростом и «забивают» колонии стрептококков.
-
Во-вторых, данным методом не выделяются ослабленные стрептококки, что характерно для хронических тонзиллитов и после неадекватной АБТ.
-
В-третьих, во многих лабораториях для посева микроорганизмов используются питательные среды с добавлением донорской крови, а донорская кровь может содержать антитела к БГСА, которые препятствуют росту этих микроорганизмов.
-
В- четвертых, важно помнить, что использование на амбулаторном этапе антибиотиков (даже их однократный прием) резко уменьшает вероятность выделения возбудителя бактериологическим методом, т.к. БГСА очень чувствителен к АБ и не даст роста.
В настоящее время широкое распространение получили методы экспресс-диагностики стрептококкового антигена в мазках с поверхности миндалин и/или задней стенки глотки (Streptotest), которые позволяют получать результат уже через несколько минут.
В западных странах данные тесты давно вошли в стандарты диагностики острых воспалений горла и в ежедневную практику врачей – они есть в кабинете у каждого семейного врача.
В соответствии с рекомендациями ESCMID (Европейского общества по клинической микробиологии и инфекционным заболеваниям) культуральное исследование мазка (посев) на БГСА не рекомендуется как рутинное у всех пациентов с острой болью в горле. При высокой вероятности БГСА следует провести экспресс-диагностику. В случае отрицательного результата экспресс-теста, бактериологическое исследование не проводится.
No-step Strep A - это израильский стрептотест, позволяющий выявить БГСА в горле за 5 минут. Это уникальный в мире тест, очень простой в использовании и не требующий специальной подготовки. Тест может быть выполнен в кабинете врача, у постели пациента и даже дома, поскольку любая мама может сделать это индивидуально и информировать врача о результате.

Преимущества экспресс-теста No-Step Strep A
-
мгновенный результат – через 5 минут;
-
чувствительность - 98%;
-
точность диагностики - 99,1%;
-
выявляет антиген даже из ослабленных (погибших) стрептококков
-
индивидуальный (1 тест продается в отдельной коробке);
-
очень простой в исполнении;
-
исключены человеческие ошибки (реакция происходит внутри устройства);
-
имеет все необходимое в комплекте (включая стерильную тампонную палочку);
-
не требует хранения в холодильнике (его можно брать с собой в поездку);
И самое важное: с одной стороны, No-Step Strep A позволяет снизить необоснованную антибиотикотерапию на 43%, а с другой- своевременно начать лечение при стрептококковой ангине и избежать осложнений.
No-Step Strep A произведен в Израиле в соответствии с самыми высокими в мире стандартами качества, экспортируется в более чем 40 стран. Тест прошел клинические и лабораторные испытания, имеет все международные сертификаты качества и официально зарегистрирован в Республике Молдова.

ВНИМАНИЕ: ПОСЛЕ ПРОВЕДЕНИЯ ТЕСТА СООБЩИТЕ ВАШЕМУ ВРАЧУ О РЕЗУЛЬТАТЕ! ИЗБЕГАЙТЕ САМОЛЕЧЕНИЯ!
Экспресс-тест на бета-гемолитический стрептококк No-Step Strep A доступен в аптеках Молдовы: Farmacia familiei, Orient, Apoteka.
Узнай больше ЗДЕСЬ.
























